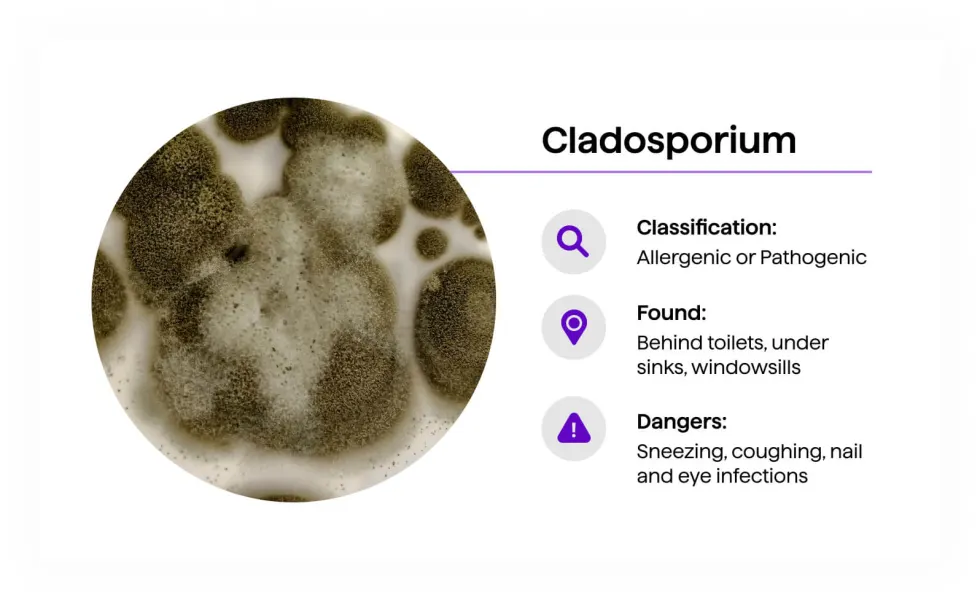
Cladosporium mold — olive green to dark brown, powdery texture
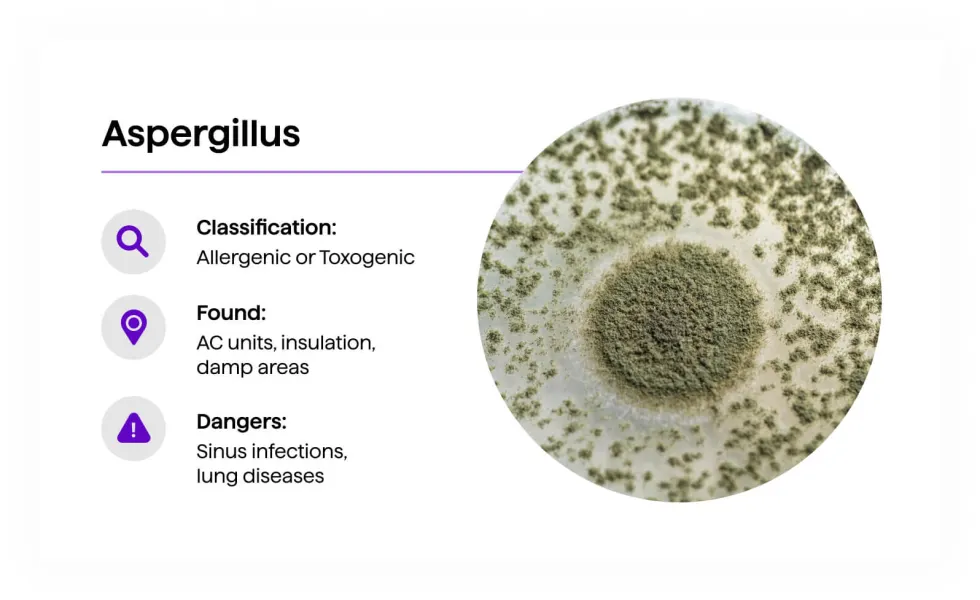
Aspergillus mold — powdery green colony with spore-dotted surface
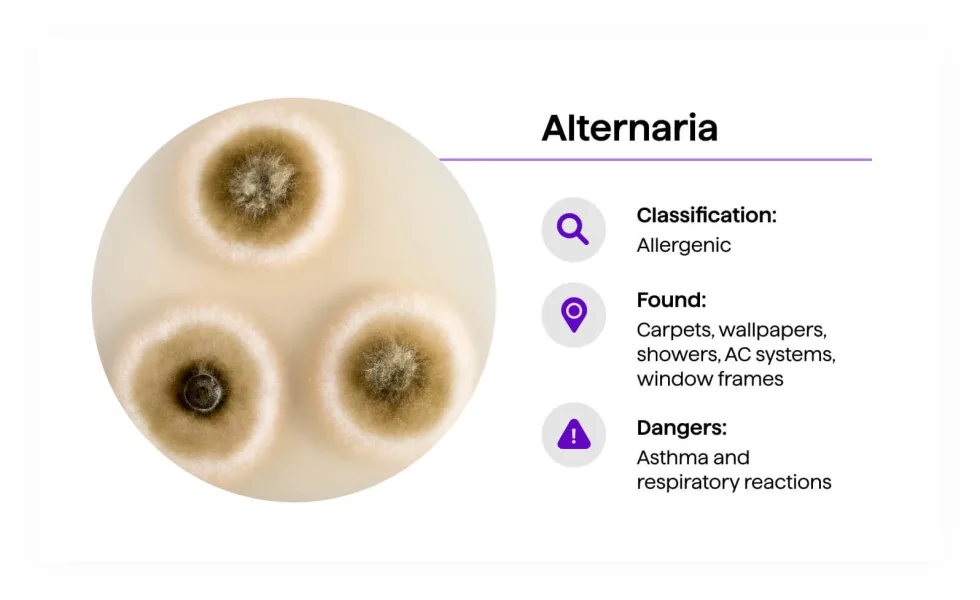
Alternaria mold — dark brown woolly colonies with defined circular growth pattern
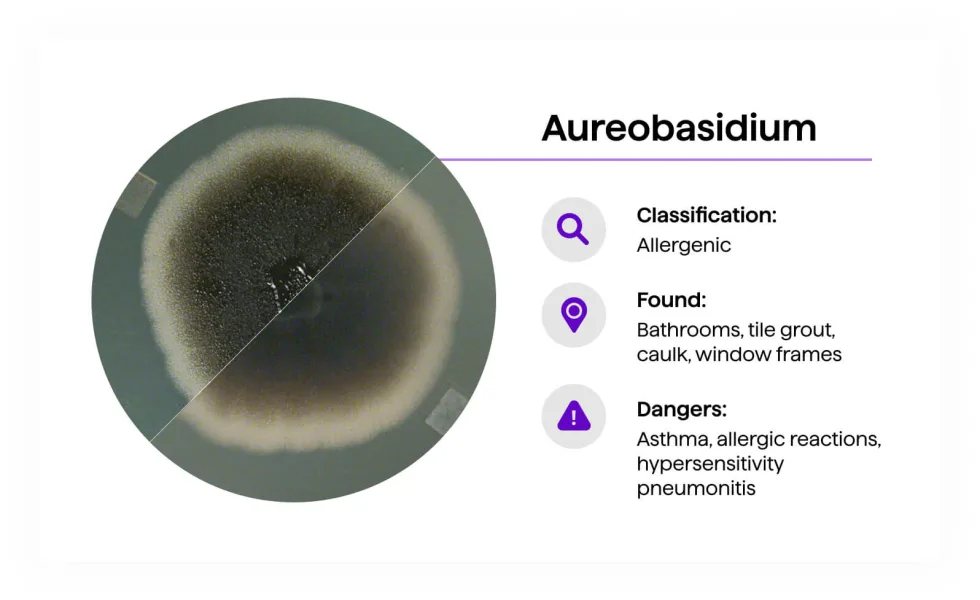
Aureobasidium mold — dark greenish-black colony, gradient from center to lighter edge
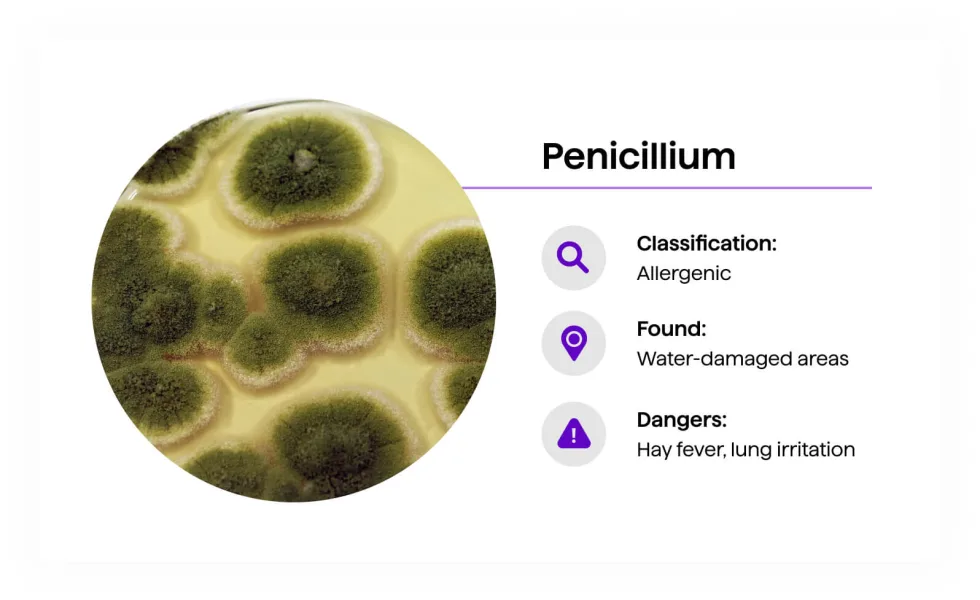
Penicillium mold — circular green colonies with concentric ring patterns
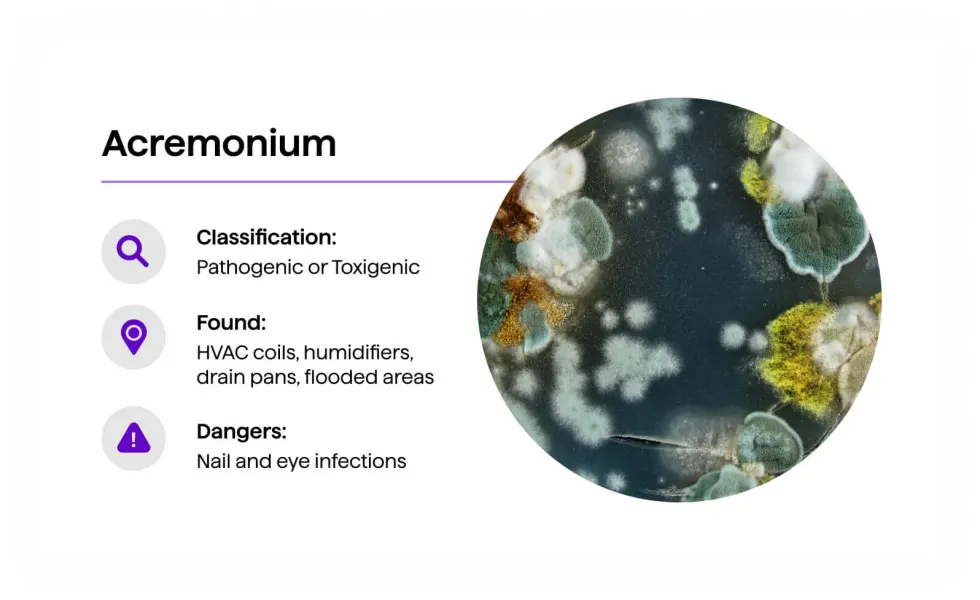
Acremonium mold — mixed white, gray, and green colonies in culture
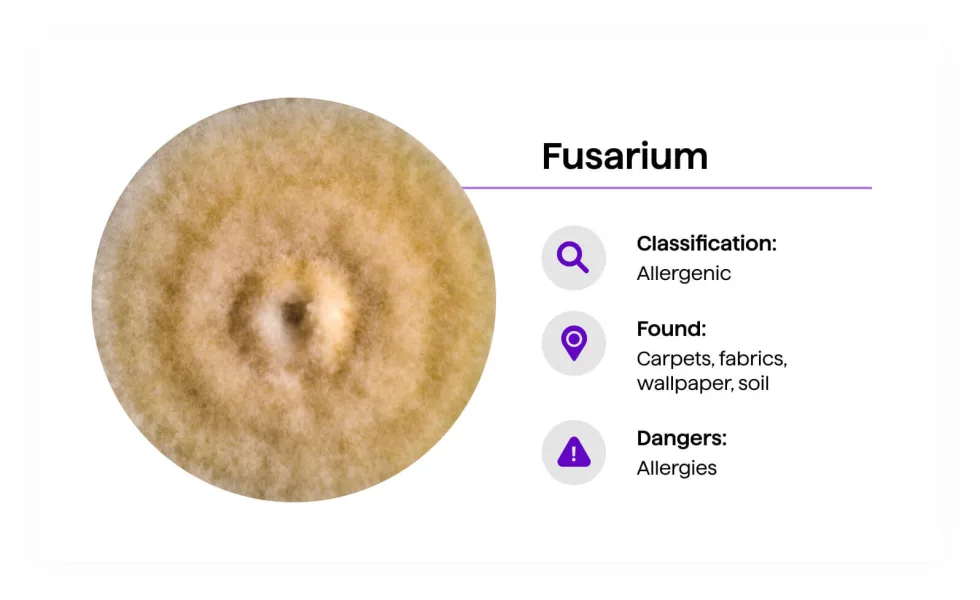
Fusarium mold — tan to brown circular colony with lighter center
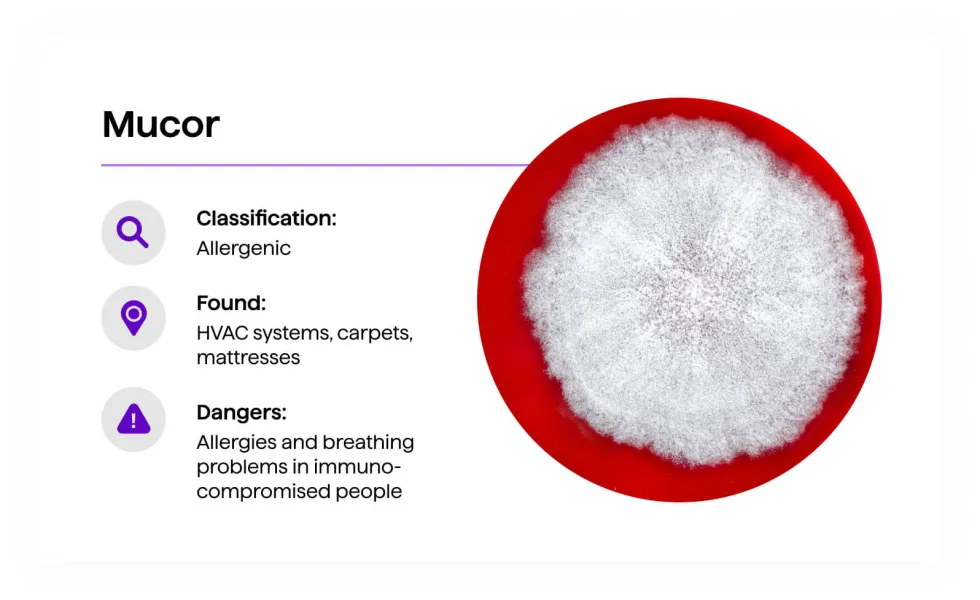
Mucor mold — dense white fluffy growth filling circular culture dish

After 15 years of remodeling Colorado Springs homes, I’ve opened a lot of walls, pulled a lot of tile, and found a lot of things growing in damp spaces. What I’ve rarely found is the terrifying black mold that dominates home improvement forums and late-night news. What I find regularly is Aureobasidium on grout and caulk, Cladosporium on windowsills, and Aspergillus around HVAC components — common, manageable, and very different from Stachybotrys chartarum.
Colorado’s dry climate makes this market unusual. Understanding what actually grows here, what requires genuine alarm, and what’s a cleaning problem is the most useful thing I can offer before you reach for the phone or the bleach.
The Colorado Context: Why True Black Mold Is Rare Here
Stachybotrys chartarum — the “toxic black mold” — requires sustained humidity above 90% and a constant moisture source. It is slow-growing and doesn’t compete well against other mold species under normal conditions.
Colorado Springs indoor humidity runs 10–20% in winter. That’s one of the least hospitable environments for Stachybotrys in the country. It can still appear — but only after prolonged, active water intrusion: a persistent roof leak ignored for months, a basement with standing water, a slab plumbing failure that saturated a wall for weeks. The kind of moisture that’s obvious and urgent, not ordinary bathroom condensation.
The dark stuff on your shower grout almost certainly isn’t Stachybotrys. That doesn’t mean you ignore it — all mold is a moisture indicator, and all of it requires removal and a fix to the underlying cause.
The Mold Species Guide: What You’re Actually Looking At
Cladosporium
Cladosporium — olive green to dark brown, powdery or suede-like texture. The most common outdoor mold in Colorado, frequently found indoors on windowsills and wood surfaces.
Classification: Allergenic or Pathogenic · Found: Windowsills, wood, insulation, fabrics, behind toilets, under sinks · Health risks: Sneezing, coughing, nail and eye infections
The most common outdoor mold in Colorado, Cladosporium migrates indoors readily and thrives at lower temperatures than most molds — active during Colorado’s cool shoulder seasons when other species aren’t. In local homes it colonizes windowsills where condensation forms on cold glass, wood surfaces in attics with inadequate ventilation, and anywhere organic material stays periodically damp.
Aspergillus
Aspergillus — powdery texture, commonly green but appears in many colors. Found in HVAC systems and damp areas throughout Colorado homes.
Classification: Allergenic or Toxigenic (species-dependent) · Found: HVAC ducts, AC coils, insulation, humidifiers, damp areas · Health risks: Sinus infections, lung irritation; serious lung disease in immunocompromised individuals
Aspergillus encompasses hundreds of species and is among the most common indoor molds globally. It can grow with minimal moisture — significant in Colorado where other molds struggle. In Colorado Springs homes, HVAC components and whole-home humidifier water panels are primary colonization points. Humidifier panels should be replaced at each heating season startup.
Alternaria
Alternaria — dark olive-brown, woolly texture with circular colony growth. The leading cause of mold allergies in Colorado, peaking during monsoon season July–September.
Classification: Allergenic · Found: Carpets, wallpaper, showers, AC systems, window frames · Health risks: Asthma and respiratory reactions — the leading mold allergen in Colorado
Alternaria is primarily an outdoor mold but migrates indoors readily. A 2011 Quest Diagnostics allergy study identified Denver as a top-10 worst U.S. city for mold allergies, driven largely by Alternaria. In Colorado Springs it spikes during monsoon months (July–September) when outdoor humidity climbs. Found indoors in damp bathroom corners, under sinks, and in basements with humidity issues.
Aureobasidium
Aureobasidium — ranges from pink-brown when young to dark greenish-black as it matures. The most common mold found on bathroom grout and caulk in Colorado Springs homes.
Classification: Allergenic · Found: Bathroom tile grout, caulk lines, window frames · Health risks: Asthma, allergic reactions, hypersensitivity pneumonitis
Aureobasidium is almost certainly what’s growing on your shower grout and caulk. It starts pinkish-brown and darkens to near-black as it matures — which is why homeowners frequently mistake it for Stachybotrys. It’s a surface organism that responds to proper cleaning and grout sealing. At Colorado Springs’ 11.7 gpg hard water, mineral deposits in unsealed grout create an ideal growth substrate. Sealed grout breaks the cycle.
Penicillium
Penicillium — distinctive circular green colonies with concentric ring patterns. Spreads rapidly and is common in any area with past water damage.
Classification: Allergenic · Found: Water-damaged drywall, insulation, carpet, wallpaper · Health risks: Hay fever, lung irritation, chronic sinus issues
Penicillium spreads rapidly once established and is common in any Colorado Springs home with past water damage — a leaky window, a prior roof issue, a bathroom with inadequate ventilation. Unlike surface mildew, Penicillium penetrates porous materials and requires removal of the affected substrate, not just surface cleaning.
Chaetomium

Chaetomium — dark, hairy, cotton-like texture found on water-damaged drywall and structural wood. Its presence indicates significant water intrusion history.
Classification: Allergenic or Pathogenic · Found: Drywall, structural beams, wallpaper, water-damaged areas · Health risks: Allergies, asthma, hay fever; some species considered carcinogenic at high exposure
Chaetomium grows on cellulose materials after significant water intrusion — drywall, wood, wallpaper. Its appearance is distinctive: dark, cotton-like, with visible hair-like filaments. In Colorado Springs it appears in homes with past roof leaks, basement flooding, or long-standing plumbing failures. Its presence signals substrate damage severe enough to require material removal, not surface treatment.
Acremonium
Acremonium — white or gray when young, developing color over time. Found in HVAC drain pans and humidifiers — equipment common in Colorado Springs' dry climate.
Classification: Pathogenic or Toxigenic · Found: HVAC coils and drain pans, humidifiers, window sealants, flooded areas · Health risks: Nail and eye infections; systemic infection risk for immunocompromised individuals
Acremonium is particularly relevant in Colorado Springs because it colonizes whole-home humidifiers and HVAC drain pans — equipment that’s common here because of our dry climate. A neglected humidifier water panel is a reliable Acremonium growth site. Replace the panel each heating season startup.
Fusarium
Fusarium — tan to brown, soil-associated. Grows at colder temperatures than most molds, making it active in Colorado during months other species are dormant.
Classification: Allergenic · Found: Carpets, fabrics, wallpaper, soil — often tracked in from outside · Health risks: Allergies, skin and eye irritation
Fusarium enters homes on footwear and through air movement. It grows at colder temperatures than most molds — active in Colorado during seasons others are dormant. Most common in carpeted entryway areas and basement spaces with soil contact. Regular HEPA vacuuming is the primary control.
Mucor
Mucor — white to gray, dense and fluffy. Grows rapidly when conditions allow. Found in HVAC systems and on damp organic material.
Classification: Allergenic · Found: HVAC systems, carpets, mattresses, decaying organic material · Health risks: Allergies and breathing problems, more serious in immunocompromised individuals
Mucor grows rapidly and is associated with HVAC systems that haven’t been serviced, damp carpets, and old mattresses in basement storage. It can grow at cooler temperatures, relevant in Colorado’s cold months. Primary prevention is HVAC maintenance and eliminating moisture sources.
Trichoderma

Trichoderma — bright green, rapid-growing. Attacks damp wood and building materials, producing enzymes that break down cellulose and cause structural damage.
Classification: Allergenic · Found: Damp wood, baseboards, carpets, wallpaper, damp building materials · Health risks: Severe allergies, lung infections, asthma
Trichoderma attacks damp wood and wood-based building materials, producing enzymes that break down cellulose — meaning it can cause structural damage if moisture conditions persist. In Colorado Springs homes it appears on baseboards, subflooring near plumbing leaks, and wood structural members in crawlspaces. Its bright green color is distinctive. Presence indicates an active moisture problem that requires correction.
Ulocladium

Ulocladium — dark brown to black, smooth rounded colonies. Requires high moisture to establish — found after flooding events and significant water intrusion.
Classification: Allergenic · Found: Flooded areas, kitchens, basements, highly damp surfaces · Health risks: Respiratory issues, asthma, hay fever
Ulocladium requires high moisture to establish and is less common in Colorado Springs than in humid markets. It appears after significant water events — basement flooding, dishwasher failures, extended roof leaks. It’s frequently found alongside Stachybotrys in severely water-damaged buildings because they share moisture requirements. Its presence suggests a more serious water event than typical condensation.
Stachybotrys Chartarum — True Black Mold

Stachybotrys chartarum on water-damaged drywall. Irregular spreading dark patches with a slimy appearance when wet — distinctly different from the neat circular colonies of other mold species. Requires sustained water intrusion to establish.
Classification: Toxigenic · Found: Wet drywall, ceiling tiles, basements, areas with prolonged water damage · Health risks: Mycotoxin production; respiratory and neurological symptoms at high exposure
A few things worth knowing that media coverage omits:
The CDC’s position is that Stachybotrys should be treated like any other mold — remove it and fix the moisture source. No test proves an association between Stachybotrys and specific health symptoms. The 1990s panic was triggered by a CDC report later withdrawn after reanalysis failed to confirm the connection to infant deaths. Major health organizations including the CDC, WHO, and AAAAI agree that while Stachybotrys can cause allergic and respiratory symptoms, evidence for severe mycotoxicosis from typical indoor exposure remains inconclusive.
That said: its presence always indicates a serious, prolonged water problem requiring professional remediation regardless of the health risk debate.
What it actually looks like: Dark greenish-black, slimy or gelatinous when wet. Irregular patches with color variation — lighter at the younger spreading edges, darker at the established center. Strong musty-earthy odor that hits you when entering the space. Grows on paper-faced drywall, wood, ceiling tile — not on ceramic, glass, or non-porous surfaces.
In 15 years of Colorado remodeling: I’ve found it once — behind drywall in a basement with a concealed, prolonged sewer backup. The conditions were unmistakable before I opened a single wall.
What’s Actually on Your Shower Grout
The black stuff on grout is almost certainly Aureobasidium — a surface organism that darkens as it matures and responds to proper cleaning. The flat powdery gray growth is surface mildew. Neither is Stachybotrys.
Bleach test: Apply a drop of household bleach. Lightens within 1–2 minutes = mold or mildew. Dirt won’t change color.
Texture test: Mildew is flat and powdery. Mold is raised and fuzzy or slimy. Stachybotrys specifically is slimy, not powdery — and grows on drywall and wood, not on tile.
Return test: Surface mildew cleaned from unsealed grout comes back because the grout is still porous. Mold that returns after cleaning despite fixing visible moisture suggests a hidden colony behind the surface.
What to Do
Surface mildew and Aureobasidium on grout: Oxygen bleach paste applied with a grout brush, covered with plastic wrap, left 4–8 hours. Rinse. Apply penetrating grout sealer once dry. The sealer breaks the cycle — unsealed grout in Colorado Springs hard water is a guaranteed repeat problem.
Small contained mold on non-porous surfaces (under 10 sq ft): N95 mask, nitrile gloves, eye protection. Mold-killing cleaner. Fix the moisture source. EPA guidance supports DIY at this scope on non-porous surfaces.
Mold on drywall or wood: Drywall with mold growth typically requires removal — you cannot surface-clean penetrating mold out of paper-faced drywall. Cut out and replace affected sections. Treat framing with borax solution before closing.
Call a professional when: Area exceeds 10 square feet, musty smell without visible source, mold in HVAC or ductwork, significant water intrusion history, or anyone in the household has respiratory conditions or immune compromise.
For mold found during a bathroom or remodel project in Colorado Springs, call (719) 243-9718.
Sources: CDC Mold Health (cdc.gov/mold-health); CDC Facts About Stachybotrys chartarum; Colorado Allergy and Asthma Centers; WebMD Mold Reference. Mold identification images sourced from mold reference library.
Ready to Get Started?
Flat-rate written estimate, no hourly surprises. Serving Colorado Springs, Monument, Fountain, Woodland Park, and the Pikes Peak region.